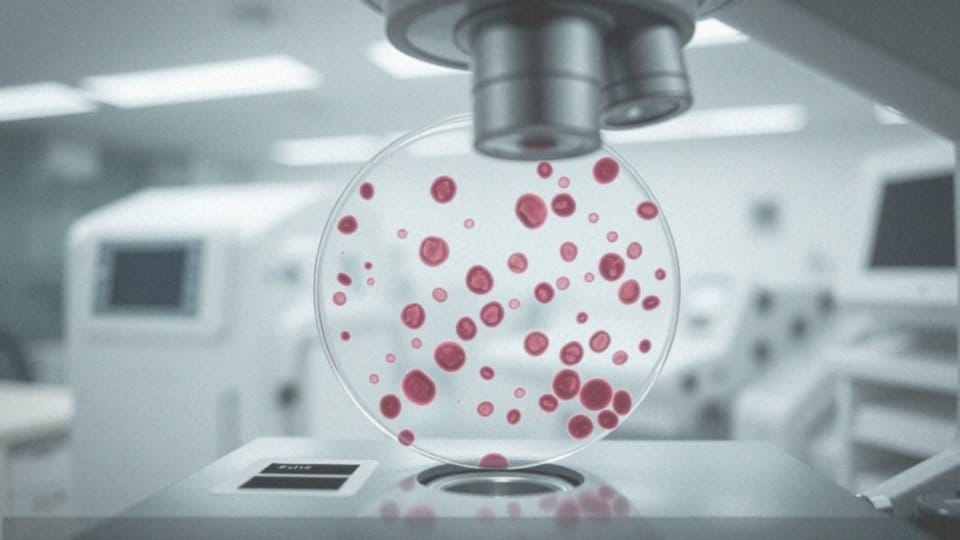

Spis treści
Czy małopłytkowość jest groźna?
Małopłytkowość stanowi istotny problem zdrowotny, zwłaszcza w sytuacjach, gdy liczba płytek krwi drastycznie maleje. Zredukowana ilość płytek znacznie podnosi ryzyko wystąpienia krwawień, w tym szczególnie niebezpiecznych epizodów, takich jak:
- krwotok z przewodu pokarmowego,
- krwotok z ośrodkowego układu nerwowego.
Takie sytuacje mogą zagrażać życiu pacjenta. Nawet umiarkowana małopłytkowość zasługuje na stałe monitorowanie, gdyż może być wczesnym symptomem poważniejszych problemów zdrowotnych. Polegająca na obniżonej liczbie płytek, małopłytkowość wpływa negatywnie na hemostazę — proces niezbędny do prawidłowego krzepnięcia krwi. W przypadku braku adekwatnego leczenia, ryzyko wewnętrznych krwawień się zwiększa, co w niektórych przypadkach może prowadzić do groźnych powikłań zdrowotnych.
Co to jest małopłytkowość?
Małopłytkowość, znana także jako trombocytopenia, to stan, w którym poziom płytek krwi spada poniżej 150 × 10^9/l. Płytki krwi odgrywają niezwykle ważną rolę w procesie krzepnięcia oraz w naprawie uszkodzonych tkanek. Gdy ich ilość jest niewystarczająca, organizm ma trudności w powstrzymywaniu krwawień, co może prowadzić do poważnych konsekwencji zdrowotnych.
Istnieją dwa podstawowe typy małopłytkowości:
- forma nabyta, która może być wywołana przez różnorodne czynniki, takie jak choroby autoimmunologiczne, infekcje, przyjmowanie niektórych leków lub nadużywanie alkoholu,
- forma wrodzona, która wiąże się najczęściej z genetycznymi uwarunkowaniami.
Do przyczyn obniżonej liczby płytek krwi można zaliczyć:
- ich nadmierne niszczenie,
- niewystarczającą produkcję w szpiku kostnym,
- nieprawidłowy rozkład w organizmie.
Małopłytkowość zazwyczaj diagnozowana jest podczas rutynowego badania morfologii krwi obwodowej. To podstawowe badanie dostarcza cennych informacji zarówno o przyczynach, jak i o potencjalnych skutkach zdrowotnych związanych z tym schorzeniem.
Jakie są główne przyczyny małopłytkowości?
Małopłytkowość występuje z różnorodnych powodów, które można pogrupować w kilka kategorii. Pierwszym aspektem są zaburzenia szpiku kostnego, takie jak:
- białaczka,
- nowotwory,
- anemia aplastyczna,
które skutkują ograniczoną produkcją płytek krwi. Również wirusy, jak te wywołujące zapalenie wątroby typu C i HIV, mają negatywny wpływ na ich ilość. Choroby autoimmunologiczne, w tym toczeń rumieniowaty układowy oraz reumatoidalne zapalenie stawów, mogą prowadzić do sytuacji, w której układ odpornościowy zaczyna atakować własne komórki krwi. Ponadto, niektóre leki, w szczególności heparyna, mogą zwiększać proces niszczenia płytek.
W przypadkach bardziej skrajnych, takich jak zakrzepowa plamica małopłytkowa lub zespół hemofagocytowy, zaobserwować można znaczący spadek ich liczby, co wymaga szybkiej reakcji medycznej. Warto również wspomnieć, że niedobory witamin, na przykład B12 i kwasu foliowego, odgrywają istotną rolę w rozwoju tego stanu. Dodatkowo, choroby wątroby i problemy genetyczne, takie jak zespół Wiskotta-Aldricha, mogą przyczynić się do małopłytkowości.
W ciąży, stan przedrzucawkowy oraz powiększenie śledziony także są ważnymi czynnikami wiążącymi się z tym schorzeniem. Kluczowe jest zrozumienie tych przyczyn, aby móc ocenić zdrowotne konsekwencje związane z małopłytkowością.
Jakie są objawy małopłytkowości?
Objawy małopłytkowości mogą różnić się w zależności od tego, jak bardzo spadła liczba płytek krwi. Kiedy ich poziom osiąga wartość poniżej 150 000/µl, można zauważyć szereg symptomów. Najczęściej pacjenci skarżą się na:
- łatwe powstawanie siniaków,
- wybroczyny, które mają postać małych, czerwonych lub fioletowych kropek na skórze,
- krwawienia z błon śluzowych, takie jak krwotoki z nosa czy krwawienie dziąseł,
- przedłużone krwawienie po niewielkich urazach,
- obfite miesiączki u kobiet, co może prowadzić do ryzyka anemii z powodu utraty krwi.
W bardziej zaawansowanych przypadkach można zauważyć krwiomocz czy krwawienia z układu pokarmowego, które stanowią poważne zagrożenie dla życia i wymagają pilnej pomocy medycznej. Wewnętrzne krwawienia są szczególnie niebezpieczne, gdy liczba płytek krwi spadnie poniżej 30 000/µl. Dlatego tak istotne jest monitorowanie tych objawów, aby możliwe było wczesne rozpoznanie i skuteczne leczenie małopłytkowości.
Jak diagnozuje się małopłytkowość?
Diagnostyka małopłytkowości, inaczej nazywanej trombocytopenią, opiera się na kilku kluczowych badaniach. Pierwszym krokiem jest analiza morfologii krwi obwodowej, która umożliwia nam obliczenie liczby płytek krwi. Jeżeli wynik wynosi mniej niż 150 × 10^9/l, oznacza to małopłytkowość, co uruchamia kolejne etapy diagnostyczne.
Kolejnym krokiem są badania biochemiczne. Te badania oceniają funkcje narządów oraz pomagają zidentyfikować potencjalne zaburzenia metaboliczne. W sytuacji, gdy istnieją wątpliwości dotyczące przyczyn niskiej liczby płytek, można przeprowadzić biopsję szpiku kostnego lub trepanobiopsję. Te procedury pozwalają na dokładniejszą ocenę struktury szpiku oraz mogą ujawniać poważniejsze problemy, takie jak białaczka.
Ustalenie dokładnej diagnozy małopłytkowości jest niezwykle istotne, ponieważ zrozumienie przyczyny jest kluczowe dla wdrożenia skutecznego leczenia. Przyczyny problemu mogą być różnorodne, obejmując m.in.:
- nadmierne niszczenie płytek,
- niewłaściwą produkcję w szpiku kostnym,
- choroby ogólnoustrojowe.
Zrozumienie tych mechanizmów pozwala na lepsze dostosowanie terapii, co z kolei zmniejsza ryzyko wystąpienia powikłań zdrowotnych.
Czy małopłytkowość jest samodzielną chorobą czy objawem innej choroby?
Małopłytkowość to stan, który oznacza obniżoną liczbę płytek krwi. Może występować jako odrębna choroba, tak jak małopłytkowość immunologiczna, albo być symptomem innych dolegliwości. Często jej przyczyny można odnaleźć w chorobach autoimmunologicznych, takich jak:
- toczeń rumieniowaty układowy,
- reumatoidalne zapalenie stawów.
Dodatkowo, infekcje wirusowe, na przykład HIV czy wirusowe zapalenie wątroby typu C, mogą również prowadzić do zmniejszenia ilości płytek krwi. Inne potencjalne przyczyny to:
- białaczka,
- nowotwory szpiku kostnego.
W diagnostyce małopłytkowości istotne jest przeprowadzenie dokładnych badań, które pomogą zidentyfikować źródło problemu. Ten proces może obejmować badania:
- morfologiczne,
- biochemiczne,
- biopsję szpiku kostnego.
Należy również zwrócić uwagę na różnicowanie między przyczynami nabytymi a wrodzonymi. Skuteczne leczenie małopłytkowości w dużej mierze zależy od ustalonej przyczyny, co z kolei wpływa na wybór odpowiedniej terapii oraz prognozy dla pacjenta. Zrozumienie tych kwestii jest kluczowe dla dalszego postępowania klinicznego oraz oceny stanu zdrowia pacjenta.
Jak małopłytkowość wpływa na zdolność krzepnięcia krwi?
Małopłytkowość odgrywa kluczową rolę w zdolności krwi do krzepnięcia. Płytki krwi, zwane trombocytami, są niezbędne do hemostazy, czyli procesu, który zapobiega krwawieniom. Kiedy ich liczba spada poniżej 150 × 10^9/l, proces tworzenia czopów płytkowych przy uszkodzeniach naczyń staje się znacznie utrudniony.
W efekcie wydłuża się czas krwawienia, co wiąże się z wyższym ryzykiem zarówno krwawień wewnętrznych, jak i zewnętrznych. Czasami, gdy poziom płytek spada poniżej 30 000/µl, niebezpieczeństwo poważnych krwawień znacznie rośnie. Nawet drobne urazy mogą prowadzić do groźnych komplikacji zdrowotnych, takich jak:
- krwotoki z przewodu pokarmowego,
- krwawienia z nosa.
Osoby cierpiące na małopłytkowość wymagają szczególnej troski oraz regularnych badań, ponieważ brak odpowiedniego leczenia może prowadzić do poważnych komplikacji zagrażających życiu. Mimo że organizm dysponuje innymi mechanizmami regulującymi krwawienie, w przypadkach zaawansowanej małopłytkowości zazwyczaj nie są one wystarczająco skuteczne. Dlatego tak istotne jest szybkie wdrożenie leczenia oraz systematyczne monitorowanie stanu zdrowia pacjenta, co może znacząco wpłynąć na jakość życia i bezpieczeństwo zdrowotne.
Czy ktoś z małopłytkowością ma zwiększone ryzyko krwawień?
Osoby cierpiące na małopłytkowość są narażone na wyższe ryzyko krwawień, co wynika z zmniejszonej liczby płytek krwi. W miarę spadku ich poziomu, zarówno samoistne, jak i urazowe krwawienia stają się coraz bardziej prawdopodobne. Takie krwawienia mogą przybierać różne formy – od:
- wybroczyn na skórze,
- krwawień z nosa i dziąseł,
- poważniejszych przypadków, takich jak krwawienie z przewodu pokarmowego czy krwiomocz.
W szczególności krwawienia do ośrodkowego układu nerwowego są wyjątkowo niebezpieczne i mogą zagrażać życiu. Gdy poziom płytek spada poniżej 30 000/µl, ryzyko wystąpienia krwawień dodatkowo rośnie, co sprawia, że nawet niewielkie urazy mogą prowadzić do poważnych konsekwencji. Dlatego niezwykle istotne jest regularne monitorowanie stanu zdrowia oraz stosowanie odpowiedniego leczenia, które zminimalizuje ryzyko groźnych powikłań. Osoby z tym schorzeniem powinny pozostawać pod stałą opieką medyczną, co pozwoli na elastyczne dostosowanie terapii do ich zmieniających się potrzeb zdrowotnych.
Czy małopłytkowość może prowadzić do krwotoków?
Małopłytkowość zwiększa ryzyko wystąpienia krwotoków, co jest efektem obniżonej liczby płytek krwi. Te niewielkie elementy mają fundamentalne znaczenie dla procesu krzepnięcia. Kiedy ich ilość spadnie poniżej 150 000/µl, pacjenci stają się znacznie bardziej narażeni na krwawienia. Możliwe są zarówno drobne krwawienia, jak:
- wybroczyny,
- krwawienia z nosa,
- jak i poważniejsze, które mogą wystąpić wewnętrznie i stanowić zagrożenie dla życia.
Krwawienia wewnętrzne mogą zagrażać zdrowiu układu pokarmowego lub ośrodkowego układu nerwowego. Im niższy poziom płytek, tym większe prawdopodobieństwo powikłań. Na przykład, kiedy liczba płytek spadnie poniżej 30 000/µl, ryzyko poważnych epizodów krwotocznych znacząco wzrasta. Nawet niewielkie urazy mogą prowadzić do niebezpiecznych sytuacji, co wymaga natychmiastowej interwencji medycznej. Z tego względu osoby z małopłytkowością powinny być systematycznie kontrolowane. Odpowiednia terapia oraz regularne monitorowanie poziomu płytek krwi mogą skutecznie zmniejszyć ryzyko krwawień. Szybka diagnostyka oraz efektywne leczenie są niezbędne do uniknięcia poważnych komplikacji.
Jakie powikłania mogą wystąpić przy małopłytkowości?
Powikłania związane z małopłytkowością mogą prowadzić do poważnych zagrożeń dla zdrowia. Gdy liczba płytek krwi drastycznie maleje, wzrasta ryzyko:
- krwawień wewnętrznych, w tym tych, które mogą zagrażać życiu,
- komplikacji neurologicznych w obrębie czaszki,
- niedokrwistości w wyniku utraty krwi, co dodatkowo osłabia organizm.
Co więcej, terapia, która ma na celu leczenie tego schorzenia, wiąże się też z dodatkowymi wyzwaniami. Na przykład pacjenci poddawani leczeniu immunosupresyjnemu, takim jak terapia steroidowa, są bardziej narażeni na infekcje. Usunięcie śledziony, czyli splenektomia, może zaburzać naturalne procesy eliminacji płytek krwi oraz zwiększać ryzyko infekcji. Długofalowe konsekwencje mogą obejmować groźby związane z poważnymi krwotokami, które w ekstremalnych sytuacjach mogą prowadzić do śmierci.
Warto również zauważyć, że kobiety w ciąży narażone są na dodatkowe komplikacje związane z małopłytkowością, co wymaga szczególnej uwagi ze strony medyków. Właściwe zarządzanie tym stanem oraz rzetelna diagnostyka są więc niezbędne, aby zminimalizować ryzyko pojawienia się poważnych problemów zdrowotnych.
Jakie metody leczenia istnieją dla małopłytkowości?

Leczenie małopłytkowości zależy od przyczyny oraz jej ciężkości. W sytuacjach łagodnych często wystarczy jedynie obserwacja, natomiast gdy liczba płytek krwi spadnie poniżej normy, konieczne stają się bardziej zaawansowane interwencje.
Zwykle stosuje się:
- kortykosteroidy, które pomagają zredukować stan zapalny i wspierają produkcję płytek,
- plazmaferezę w przypadkach wymagających natychmiastowych działań, takich jak zespół hemolityczno-mocznicowy (HUS),
- immunoglobuliny oraz leki immunosupresyjne przy chorobach autoimmunologicznych,
- transfuzję koncentratu płytek krwi przy bardzo niskim poziomie płytek,
- rozważenie przeszczepienia szpiku w przypadkach problemów z szpikiem kostnym,
- splenektomię, gdy śledziona nadmiernie niszczy płytki,
- suplementację witamin, takich jak B12 czy kwas foliowy, przy niedoborach.
Zrozumienie przyczyny małopłytkowości jest fundamentem do wyboru odpowiedniego leczenia, które będzie najlepiej dopasowane do indywidualnych potrzeb pacjenta.
Jakie są długoterminowe skutki małopłytkowości?

Długoterminowe konsekwencje małopłytkowości mogą być poważne i różnią się w zależności od jej przyczyny oraz metod leczenia. Ignorowanie tego schorzenia często prowadzi do:
- chronicznych krwawień,
- anemii,
- obniżenia jakości życia osób dotkniętych tym problemem.
Te objawy z kolei zwiększają ryzyko groźnych komplikacji zdrowotnych, w tym niebezpiecznych krwawień wewnętrznych, które mogą zagrażać życiu. Szczególnej uwagi wymaga monitorowanie pacjentów z małopłytkowością immunologiczną, ponieważ istnieje ryzyko pojawienia się innych chorób autoimmunologicznych. Długotrwała terapia, na przykład w postaci kortykosteroidów, może wiązać się z nieprzyjemnymi skutkami ubocznymi, takimi jak:
- osteoporoza,
- cukrzyca,
- zwiększona podatność na infekcje,
co tylko pogarsza ogólny stan zdrowia. Kluczowe jest więc śledzenie objawów klinicznych, takich jak krwawienia i ich lokalizacja, aby uniknąć poważnych komplikacji i poprawić komfort życia pacjenta. Dlatego osoby z małopłytkowością powinny regularnie korzystać z opieki medycznej i wykonywać kontrolne badania krwi.



